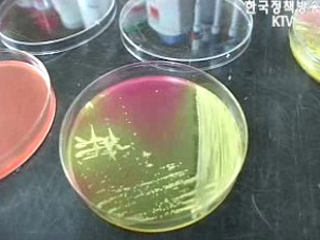
휴가철 '음식물 주의하세요!'

-
 자전거 교통사고 벌점부과 폐지
자전거 교통사고시 자동차 사고에 준해 운전자에게 벌점을 부과하는 제도가 폐지됩니다.
현행 도로교통법상 자전거는 차(車)로 분류돼 교통사고시 벌점을 부과하고, 횡단보도
사고의 경우 피해자와 합의해도 중과실로 봐서 처벌을 했는데요, 법제처는 법개정을
통해 자전거 벌점부과제를 폐지하는 등 자전거 관련 교통법규 체계 전면개편을 추진하기로
했다고 밝혔습...
방송일자 : 2008.07.22
자전거 교통사고 벌점부과 폐지
자전거 교통사고시 자동차 사고에 준해 운전자에게 벌점을 부과하는 제도가 폐지됩니다.
현행 도로교통법상 자전거는 차(車)로 분류돼 교통사고시 벌점을 부과하고, 횡단보도
사고의 경우 피해자와 합의해도 중과실로 봐서 처벌을 했는데요, 법제처는 법개정을
통해 자전거 벌점부과제를 폐지하는 등 자전거 관련 교통법규 체계 전면개편을 추진하기로
했다고 밝혔습...
방송일자 : 2008.07.22
-
 내년도 최저임금 확정고시, 시간급 4천원
내년도 최저임금이 확정,고시됐습니다.
내년도 최저임금은 시간급 4천원,하루 8시간 기준 3만2천원인데요, 사용자는 내년
1월1일부터 이 기준에 따라 지급해야 하는데요, 이에 앞서 최저임금위원회는 지난달
27일 시간급 3천770원인 올해의 최저임금을 내년에 6.1% 인상하기로 결정했습니다.(한국정책방송
KTV 위성방송 ch164, www.ktv....
방송일자 : 2008.07.22
내년도 최저임금 확정고시, 시간급 4천원
내년도 최저임금이 확정,고시됐습니다.
내년도 최저임금은 시간급 4천원,하루 8시간 기준 3만2천원인데요, 사용자는 내년
1월1일부터 이 기준에 따라 지급해야 하는데요, 이에 앞서 최저임금위원회는 지난달
27일 시간급 3천770원인 올해의 최저임금을 내년에 6.1% 인상하기로 결정했습니다.(한국정책방송
KTV 위성방송 ch164, www.ktv....
방송일자 : 2008.07.22
-
 개인사업자 200만원 이하 관세 카드납부
고유가와 원자재난으로 어려움에 처한 중소기업 지원대책의 하나로 개인사업자의
200만원 이하 관세에 대해 신용카드 납부가 허용됩니다.
관세청은 "관세를 카드로 납부하는 것이 불가능해 납세자의 불편을 초래했다"면서
관계기관과 사전 조치를 거쳐 오는 10월부터 시행에 들어갈 계획이라고 밝혔습니다.
또 과다납부 관세에 대해 직권심사를 거쳐 환급해주는 기...
방송일자 : 2008.07.22
개인사업자 200만원 이하 관세 카드납부
고유가와 원자재난으로 어려움에 처한 중소기업 지원대책의 하나로 개인사업자의
200만원 이하 관세에 대해 신용카드 납부가 허용됩니다.
관세청은 "관세를 카드로 납부하는 것이 불가능해 납세자의 불편을 초래했다"면서
관계기관과 사전 조치를 거쳐 오는 10월부터 시행에 들어갈 계획이라고 밝혔습니다.
또 과다납부 관세에 대해 직권심사를 거쳐 환급해주는 기...
방송일자 : 2008.07.22
-
 휴가철 '음식물 주의하세요!'
먹을거리 안전을 위해 정부가 다각적인 노력을 기울이고 있는데요, 특히 본격적인
여름 휴가철을 맞아 전국 고속도로 휴게소와 역에 대해서 집중적인 위생점검을 벌이고
있습니다.
식중독을 막기 위해서는 판매자와 소비자 모두 철저한 사전 위생 점검이 중요한데요,
<생활과 정책> 오늘은 휴가철 식중독을 피하는 방법을 알려드립니다.(한국정책방송
KTV ...
방송일자 : 2008.07.22
휴가철 '음식물 주의하세요!'
먹을거리 안전을 위해 정부가 다각적인 노력을 기울이고 있는데요, 특히 본격적인
여름 휴가철을 맞아 전국 고속도로 휴게소와 역에 대해서 집중적인 위생점검을 벌이고
있습니다.
식중독을 막기 위해서는 판매자와 소비자 모두 철저한 사전 위생 점검이 중요한데요,
<생활과 정책> 오늘은 휴가철 식중독을 피하는 방법을 알려드립니다.(한국정책방송
KTV ...
방송일자 : 2008.07.22
-
 정책 오늘 (35회)
지방 규제 풀고 투자 늘리고 / 행정·혁신·기업도시 발전적 보완 / 이명박 대통령, '광역적 지역발전 추구' / 함께 도약하는 지역발전 / 고유가 시대, 쓰레기도 돈 / '실효적 지배' 강화로 분쟁화 차단 / 5년간 노인성질환자 70% 증가 / 유 외교, '北에 정부간 대화 요청할 것' / 지방 미분양주택 구입시 세금 감면 / 전력사용 줄이면 지원금 받는다 / 서울↔경기 좌석버스 9월부터 환승할인 / 다산 찾아 떠나는 여행
방송일자 : 2008.07.21
정책 오늘 (35회)
지방 규제 풀고 투자 늘리고 / 행정·혁신·기업도시 발전적 보완 / 이명박 대통령, '광역적 지역발전 추구' / 함께 도약하는 지역발전 / 고유가 시대, 쓰레기도 돈 / '실효적 지배' 강화로 분쟁화 차단 / 5년간 노인성질환자 70% 증가 / 유 외교, '北에 정부간 대화 요청할 것' / 지방 미분양주택 구입시 세금 감면 / 전력사용 줄이면 지원금 받는다 / 서울↔경기 좌석버스 9월부터 환승할인 / 다산 찾아 떠나는 여행
방송일자 : 2008.07.21
-
 지방 규제 풀고 투자 늘리고
21일 첫 번째 소식은 지방의 경쟁력을 높이기 위한 전방위적인 대책이 추진된다는
소식인데요, 21일 청와대에서는 지역발전정책 추진전략 보고회의가 열렸습니다.
정부는 앞으로 지방자치단체가 기업을 적극적으로 유치해서 세수가 늘어날 경우
이를 다시 지자체에 돌려주고, 지방으로 이전하는 기업에는 각종 규제를 완화해주기로
했습니다.
정부의 신지역발전정...
방송일자 : 2008.07.21
지방 규제 풀고 투자 늘리고
21일 첫 번째 소식은 지방의 경쟁력을 높이기 위한 전방위적인 대책이 추진된다는
소식인데요, 21일 청와대에서는 지역발전정책 추진전략 보고회의가 열렸습니다.
정부는 앞으로 지방자치단체가 기업을 적극적으로 유치해서 세수가 늘어날 경우
이를 다시 지자체에 돌려주고, 지방으로 이전하는 기업에는 각종 규제를 완화해주기로
했습니다.
정부의 신지역발전정...
방송일자 : 2008.07.21
-
 행정·혁신·기업도시 발전적 보완
한편 지난 정부에서 추진을 시작한 행정중심복합도시와 혁신도시, 기업도시 등은
큰 틀에선 변화없이 더욱 보완해서 추진됩니다.
아울러, 지방국토관리청과 항만청,식품의약품안전청 등 중앙정부에 속했던 기능들이
올해 안에 지자체로 대폭 이관됩니다. 함께 보시죠~
행정중심복합도시와 혁신도시, 그리고 기업도시.
지난 정부때 시작됐던 이 사업들이 더욱 보완...
방송일자 : 2008.07.21
행정·혁신·기업도시 발전적 보완
한편 지난 정부에서 추진을 시작한 행정중심복합도시와 혁신도시, 기업도시 등은
큰 틀에선 변화없이 더욱 보완해서 추진됩니다.
아울러, 지방국토관리청과 항만청,식품의약품안전청 등 중앙정부에 속했던 기능들이
올해 안에 지자체로 대폭 이관됩니다. 함께 보시죠~
행정중심복합도시와 혁신도시, 그리고 기업도시.
지난 정부때 시작됐던 이 사업들이 더욱 보완...
방송일자 : 2008.07.21
-
 이명박 대통령, '광역적 지역발전 추구'
앞서 지역발전정책 보고회에서 보고된 주요내용 전해드렸는데요,
이명박 대통령은 이 자리에서 지역발전전략과 관련해 광역화를 강하게 언급했습니다.
지역 광역화가 세계적인 추세라면서 우리도 소 행정구역 단위의 발전전략에 벗어나야
한다고 말했는데요,
자세한 내용 전해드립니다.
이명박 대통령은 지역 발전 전략과 관련해 세계적인 추세는 광역화인 만큼 우리도 ...
방송일자 : 2008.07.21
이명박 대통령, '광역적 지역발전 추구'
앞서 지역발전정책 보고회에서 보고된 주요내용 전해드렸는데요,
이명박 대통령은 이 자리에서 지역발전전략과 관련해 광역화를 강하게 언급했습니다.
지역 광역화가 세계적인 추세라면서 우리도 소 행정구역 단위의 발전전략에 벗어나야
한다고 말했는데요,
자세한 내용 전해드립니다.
이명박 대통령은 지역 발전 전략과 관련해 세계적인 추세는 광역화인 만큼 우리도 ...
방송일자 : 2008.07.21
-
 함께 도약하는 지역발전
네, 앞서 지역발전정책 보고회의 내용 전해드렸는데요,
최근 들어서 지역발전의 중요성이 더욱 커지고 있죠?
새 정부도 심혈을 기울이고 있다는 것을 느낄 수 있는데요, 왜 지역발전이
중요하고, 이에 따른 새 정부의 방향은 무엇인지 좀더 자세하게 알아보겠습니다.
예민수> 21일 회의에서는 전해드린대로 다양한 지역발전 정책들이 나왔는데요,
그런데...
방송일자 : 2008.07.21
함께 도약하는 지역발전
네, 앞서 지역발전정책 보고회의 내용 전해드렸는데요,
최근 들어서 지역발전의 중요성이 더욱 커지고 있죠?
새 정부도 심혈을 기울이고 있다는 것을 느낄 수 있는데요, 왜 지역발전이
중요하고, 이에 따른 새 정부의 방향은 무엇인지 좀더 자세하게 알아보겠습니다.
예민수> 21일 회의에서는 전해드린대로 다양한 지역발전 정책들이 나왔는데요,
그런데...
방송일자 : 2008.07.21
-
 고유가 시대, 쓰레기도 돈
예전에는 쓰레기 처리시설 하면 대표적인 혐오시설이었잖아요.
그렇죠, 그런데 요즘같은 고유가 시대에는 쓰레기 처리시설이 환경 보전은 물론
에너지까지 생산해내서 주목을 받고 있다고 합니다.
<에너지 절약 연속기획>, 21일은 버려지는 폐열을 전력으로 바꿔 주민들에게
도움을 주고 있는 자원회수시설을 가봅니다.
한강이 시원스레 내려다보이는 지상 100...
방송일자 : 2008.07.21
고유가 시대, 쓰레기도 돈
예전에는 쓰레기 처리시설 하면 대표적인 혐오시설이었잖아요.
그렇죠, 그런데 요즘같은 고유가 시대에는 쓰레기 처리시설이 환경 보전은 물론
에너지까지 생산해내서 주목을 받고 있다고 합니다.
<에너지 절약 연속기획>, 21일은 버려지는 폐열을 전력으로 바꿔 주민들에게
도움을 주고 있는 자원회수시설을 가봅니다.
한강이 시원스레 내려다보이는 지상 100...
방송일자 : 2008.07.21